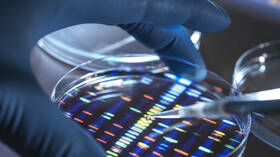
جينات عائلة كولومبية نادرة توفر سلاحا محتملا ضد مرض ألزهايمر!

أين تذهب فضلات الدماغ؟ – RT Arabic
[ad_1]
Gettyimages.ru
A Mokhtari
صورة تعبيرية
اكتشف فريق من العلماء في واشنطن أن موجة بطيئة من الكهرباء تنبض عبر الدماغ أثناء النوم، تدفع الفضلات من أعماق الدماغ إلى سطحه.
يعمل الوريد، الذي يمر عبر الدماغ، كأنبوب لنقل الفضلات عبر الحاجز الذي يفصل بين الدماغ وبقية الجسم، ما يؤدي إلى ترسيبها في مجرى الدم ليتم تصفيتها عن طريق الكلى.
ولكن، إذا توقف هذا النظام عن العمل، وهو ما يمكن أن يحدث مع التقدم في السن وفي حالات إصابات الدماغ المؤلمة والإجهاد المزمن، يمكن أن تتراكم منتجات الفضلات في الدماغ، ما قد يسمح أيضا للخلايا المناعية باختراق العضو، وبالتالي حدوث التهاب مرتبط باضطرابات الدماغ التنكسية.
وعلى الرغم من أن الدراسة أجريت على الفئران، إلا أن العلماء يعتقدون أن النتائج تتطابق مع الأبحاث حول الأسباب المحتملة لمرض ألزهايمر، وأنواع الخرف الأخرى.
وأوضح الفريق، بقيادة جوناثان كيبنيس، طبيب الأعصاب في جامعة واشنطن في سانت لويس، أن الفضلات تخرج من الدماغ عبر الحاجز الواقي الصلب دون استخدام الجهاز اللمفاوي في الجسم، وهي شبكة تستنزف السوائل في جميع أنحاء الجسم.
واكتشف العلماء نقاط خروج حول الدماغ يتدفق منها السائل النخاعي، الذي يحمل الفضلات، إلى الغشاء السميك المحيط بالدماغ والحبل الشوكي وإلى مجرى الدم، حيث تتولى الأوعية الليمفاوية في الجسم المهمة بعد ذلك.
وأفادوا أنه أثناء نوم الدماغ، تنطلق الخلايا العصبية في موجات إيقاعية متزامنة تولد القوة لتدفق السائل النخاعي وتجاوز حاجز الدم في الدماغ.
وقال الدكتور لي فينغ جيانغ شي، المعد الرئيسي للدراسة: “هذه الخلايا العصبية عبارة عن مضخات مصغرة. ويعمل النشاط العصبي المتزامن على تعزيز تدفق السوائل وإزالة الفضلات من الدماغ. إذا تمكنا من البناء على هذه العملية، فهناك إمكانية لتحقيق الوقاية من الأمراض العصبية، بما في ذلك مرض ألزهايمر وباركنسون، حيث تتراكم الفضلات الزائدة في الدماغ وتؤدي إلى التنكس العصبي”.
وفي العدد نفسه من مجلة Nature، توسع علماء معهد ماساتشوستس للتكنولوجيا في الأدلة التي تشير إلى أن الموجة البطيئة تخلّص الدماغ من الفضلات.
ووجدوا أدلة على أن تعريض الفئران المصابة بألزهايمر، لومضات الضوء والنقر الصوتي بنفس تردد إيقاع الدماغ، أدى إلى ظهور إشارات نابضة في الدماغ ساهمت في خروج السائل الدماغي الشوكي من العضو، وكان يحمل بروتين الأميلويد، الذي يتراكم في أدمغة المصابين بمرض ألزهايمر.
يذكر أن الأرق يضعف تدفق السائل الدماغي الشوكي، وكذلك التخلص من الفضلات المرتبطة بالأمراض التنكسية العصبية.
المصدر: ديلي ميل
[ad_2]
Source link